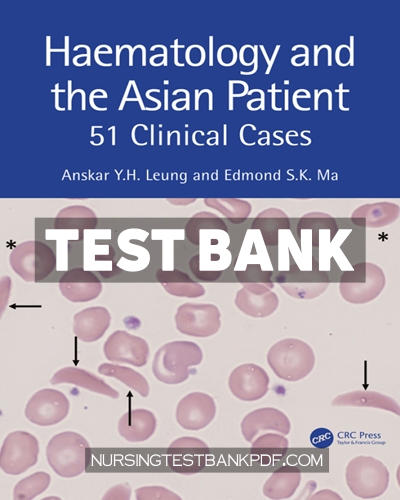
9781040038727-TEST-BANK Test Bank for Haematology and the Asian Patient 1st Edition by Leung

Test Bank for Nursing Informatics 1st Edition by Carroll
$60.00 Original price was: $60.00.$29.00Current price is: $29.00.
Test Bank for Recent Advancements in the Diagnosis of Human Disease 1st Edition by CRC Press
$60.00 Original price was: $60.00.$29.00Current price is: $29.00.
Test Bank for Haematology and the Asian Patient 1st Edition by Leung
$60.00 Original price was: $60.00.$29.00Current price is: $29.00.
Complete test bank for haematology and the asian patient 1st edition by leung. All chapters are included. Instant download.
Please enable JavaScript in your browser to complete this form.
( function() {
const style = document.createElement( 'style' );
style.appendChild( document.createTextNode( '#wpforms-11527-field_5-container { position: absolute !important; overflow: hidden !important; display: inline !important; height: 1px !important; width: 1px !important; z-index: -1000 !important; padding: 0 !important; } #wpforms-11527-field_5-container input { visibility: hidden; } #wpforms-conversational-form-page #wpforms-11527-field_5-container label { counter-increment: none; }' ) );
document.head.appendChild( style );
document.currentScript?.remove();
} )();

Please enable JavaScript in your browser to complete this form.
Choose Sample ChapterChapter 01Chapter 02Chapter 03Chapter 04
SKU:
9781040038727-TEST-BANK
Category: CRC Press Test Banks
Description
Downloadable test bank for haematology and the asian patient 1st edition by leung. All chapters are included. Instant download.
iSBN: 9781032351254,9781032351261,9781040038680,9781003325413,9781040038727.
Shipping & Delivery